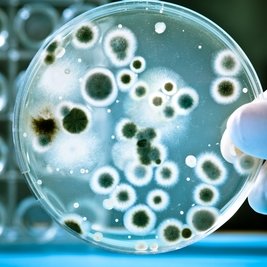
Jak postępować po odkażeniu wody?

Jak oczyścić wodę w studni?

Jak oczyścić wodę w studni?
Aby mieć pewność, że woda z naszej studni nadaje się do picia, należy co pewien czas przeprowadzać badania. Jeśli studnia zostanie skażona przez bakterie czy wirusy, stanie się źródłem groźnych chorób. Dezynfekcję należy obowiązkowo przeprowadzić w każdej nowej studni oraz w razie dokonywania jakichkolwiek napraw wymagających prac wewnątrz szybu. Odkażać trzeba również studnie na terenach zalanych przez wody powodziowe. Jak odkażać wodę w studni, dowiesz się z tego artykułu.
Dezynfekcja studni nie usuwa zanieczyszczeń chemicznych.
Podczas dezynfekowania studni należy zachować ostrożność. Trzeba założyć rękawice i okulary ochronne. Roztwór odkażający należy wlewać ostrożnie, żeby nie oblać się nim.
Przygotowanie studni do odkażania
Zanim przystąpimy do odkażania studni z kręgów, należy dokonać pomiaru jej głębokości. Za pomocą tyczki albo obciążonego ciężarkiem sznurka ustalamy, ile jest metrów od lustra wody do dna. Znając głębokość studni i jej średnicę, będziemy wiedzieli, ile przygotować środka dezynfekcyjnego. Potem trzeba oczyścić studnię. Najpierw wybieramy znajdującą się w niej wodę. Można użyć do tego pompy albo wybrać wodę wiadrem. Następnie czyścimy starannie cembrowinę studni i szorujemy kręgi. Do czyszczenia przygotowujemy roztwór wapna chlorowanego w proporcji 2 łyżeczki wapna na wiadro wody. Na koniec wybieramy zalegający na dnie piasek. Jeśli studnia nie była długo używana, należy zachować szczególną ostrożność, ponieważ na dnie mogły nagromadzić się trujące gazy.
Czym należy zdezynfekować studnię?
Wlewamy do wiadra niewielką ilość wody. Następnie dodajemy środek dezynfekcyjny – jest nim wapno chlorowane albo podchloryn sodu. Dolewamy wody do wiadra i mieszamy. Kiedy studnia ponownie napełni się wodą, wlewamy przygotowany preparat. Za pomocą tyczki albo nabierając wodę wiadrem i wlewając z powrotem, mieszamy wodę w studni, tak by preparat dotarł wszędzie. Ilość preparatu dezynfekcyjnego zależy od głębokości studni i jej średnicy. Na każdy metr głębokości wody potrzeba następującej ilości wapna chlorowanego:
* studnia o średnicy 80 cm – 150 g (jedna szklanka),
* studnia o średnicy 90 cm – 200 g (jedna szklanka i ćwierć),
* studnia o średnicy 100 cm – 250 g (półtorej szklanki),
* studnia o średnicy 120 cm – 350 g (dwie szklanki i ćwierć).
Na każdy metr głębokości wody potrzeba następującej ilości podchlorynu sodu:
* studnia o średnicy 80 cm – 300 g (dwie szklanki),
* studnia o średnicy 90 cm – 400 g (dwie i pół szklanki),
* studnia o średnicy 100 cm – 500 g (trzy szklanki),
* studnia o średnicy 120 cm – 700 g (cztery i pół szklanki).Jak zdezynfekować sieć wodociągową?
Aby zdezynfekować sieć wodociągową, należy po wlaniu środka dezynfekcyjnego do studni odkręcić wszystkie krany w budynku i spuścić wodę w toaletach, żeby ściągnąć z sieci wodę nie zawierającą tego preparatu. Kiedy poczujemy charakterystyczny zapach chloru, natychmiast zakręcamy krany. Woda powinna być poddana działaniu odkażacza przez co najmniej 8 godzin. Optymalny czas odkażania to jedna doba.
Jak postępować po odkażeniu wody?
Po upływie 24 godzin odkażanie wody należy zakończyć. Trzeba spuścić z sieci i wybrać ze studni wodę zawierającą środek dezynfekcyjny. Jeśli korzystasz z kanalizacji, odkręć krany w domu i pozwól wodzie płynąć tak długo, aż przestaniesz wyczuwać zapach chloru. Jeśli masz szambo, nie możesz wlać do niego wody z wapnem chlorowanym, gdyż doprowadziłoby to do sterylizacji szamba i zabicia wszystkich pożytecznych bakterii, rozkładających zanieczyszczenia biologiczne. Podobnie jeśli używasz ekologicznej oczyszczalni ścieków. Tak więc jeżeli masz własną kanalizację, odprowadź wodę z sieci domowej poprzez zawory znajdujące się na zewnątrz. Możesz użyć węża ogrodowego. Nie wylewaj wody na rośliny ogrodowe, nie wlewaj jej też do zbiorników czy cieków wodnych. Wodę należy odprowadzać tak długo, aż zaniknie zapach chloru. W przypadku studni kopanej wodę trzeba wybrać wiadrem albo wypompować. Przerywamy dopiero wtedy, gdy nie wyczuwamy już nawet najsłabszego zapachu chloru. Po upływie około tygodnia należy pobrać próbkę wody i oddać ją do badania, które ustali, czy nie ma w niej bakterii ani chloru.